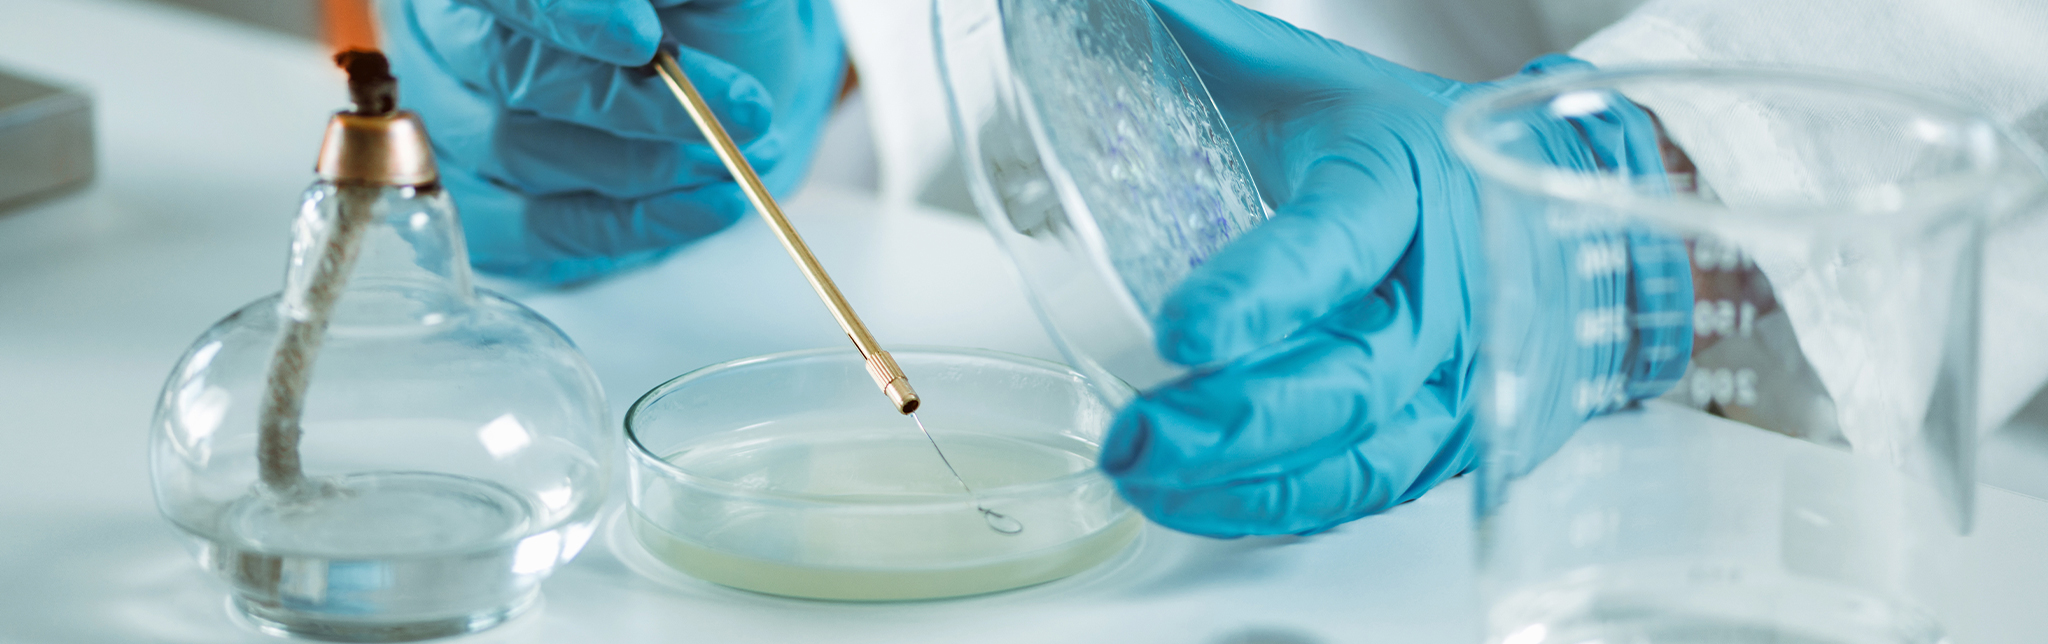

その他の微生物試験
コーガアイソトープでは、バイオバーデンの分離やMALDI-TOF MSによる迅速同定以外の微生物試験も行っておりますので、試験内容についてはお気軽にお問い合わせください。
位相差電子顕微鏡による形状観察
グラム染色
染色の結果、陽性菌は青く染色され、陰性菌は赤く染色されます。
D値測定

D値とは微生物数を1/10に減少させるのに必要な線量です。微生物の種類により、放射線に対する抵抗性が異なります。段階的な線量になるように照射して、生存菌数を測定することにより、D値を測定することができます。
| 微生物の種類 | D値(kGy) |
|---|---|
| 大腸菌 | 0.2 |
| サルモネラ・センフテンベルグ | 0.2 |
| 黒カビ | 0.5 – 0.8 |
| ブドウ球菌 | 0.7 |
| 枯草菌(芽胞) | 2.0 – 2.5 |
| Bacillus pumilus(芽胞) | 1.6 – 3.6 |
| ミクロコッカス・ラジオルランス | 2.5 |
| ボツリヌス菌 A菌 | 3.1 |
「放射線滅菌の現状と展望」,(公社)日本アイソトープ協会,
1998、「食品照射の効果と安全性」,(財)日本原子力文化振興財団,1991 より



